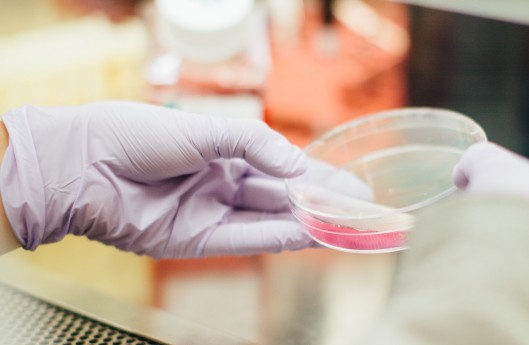

Pašlaik tiek vērtētas iespējas atrast līdzekļus mediķu algu palielināšanai, trešdien intervijā LTV “Rīta Panorāmai” sacīja Saeimas priekšsēdētāja Ināra Mūrniece (VL-TB/LNNK).
Komentējot tiesībsarga Jura Jansona aicinājumu Saeimu veikt grozījumus likumā „Par valsts budžetu 2020. gadam” un rast finansējumu, lai paaugstinātu veselības aprūpes darbinieku darba samaksu atbilstoši Saeimas pašas pieņemtajam Veselības aprūpes finansēšanas likumam, Mūrniece norādīja, ka darbs pie šī jautājuma notiek.
Pēc viņas sacītā, lielākās cerības palielināt mediķu atalgojumu saistītas ar mediķu atalgojuma modeļa pārskatīšanu, ko, kā zināms, neatbalsta Latvijas Veselības un sociālās aprūpes darbinieku arodbiedrība (LVSADA).
Kas tieši varētu mainīties, Mūrniece gan neminēja, aicinot gaidīt marta izskaņu.
Kā zināms, 2018. gada rudenī jaunievēlētā Saeima, apzinoties situācijas nopietnību, vienbalsīgi pieņēma grozījumus Veselības aprūpes finansēšanas likumā, dodot uzdevumu valdībai nākamo trīs gadu laikā mērķtiecīgi palielināt valsts finansējumu veselības aprūpes darbinieku darba samaksas paaugstināšanai vidēji par 20 procentiem gadā: 2019. gadā par 87 mlj. euro, 2020. gadā par 191 mlj. euro un 2021. gadā par 314 mlj .euro.
Lai izpildītu likumā ierakstīto, 2020.gada valsts budžetā bija nepieciešams papildu paredzēt 119 mlj. euro. Tā vietā valdība un likumdevējs lēma tikai par 60 mlj. euro finansējuma piešķiršanu.